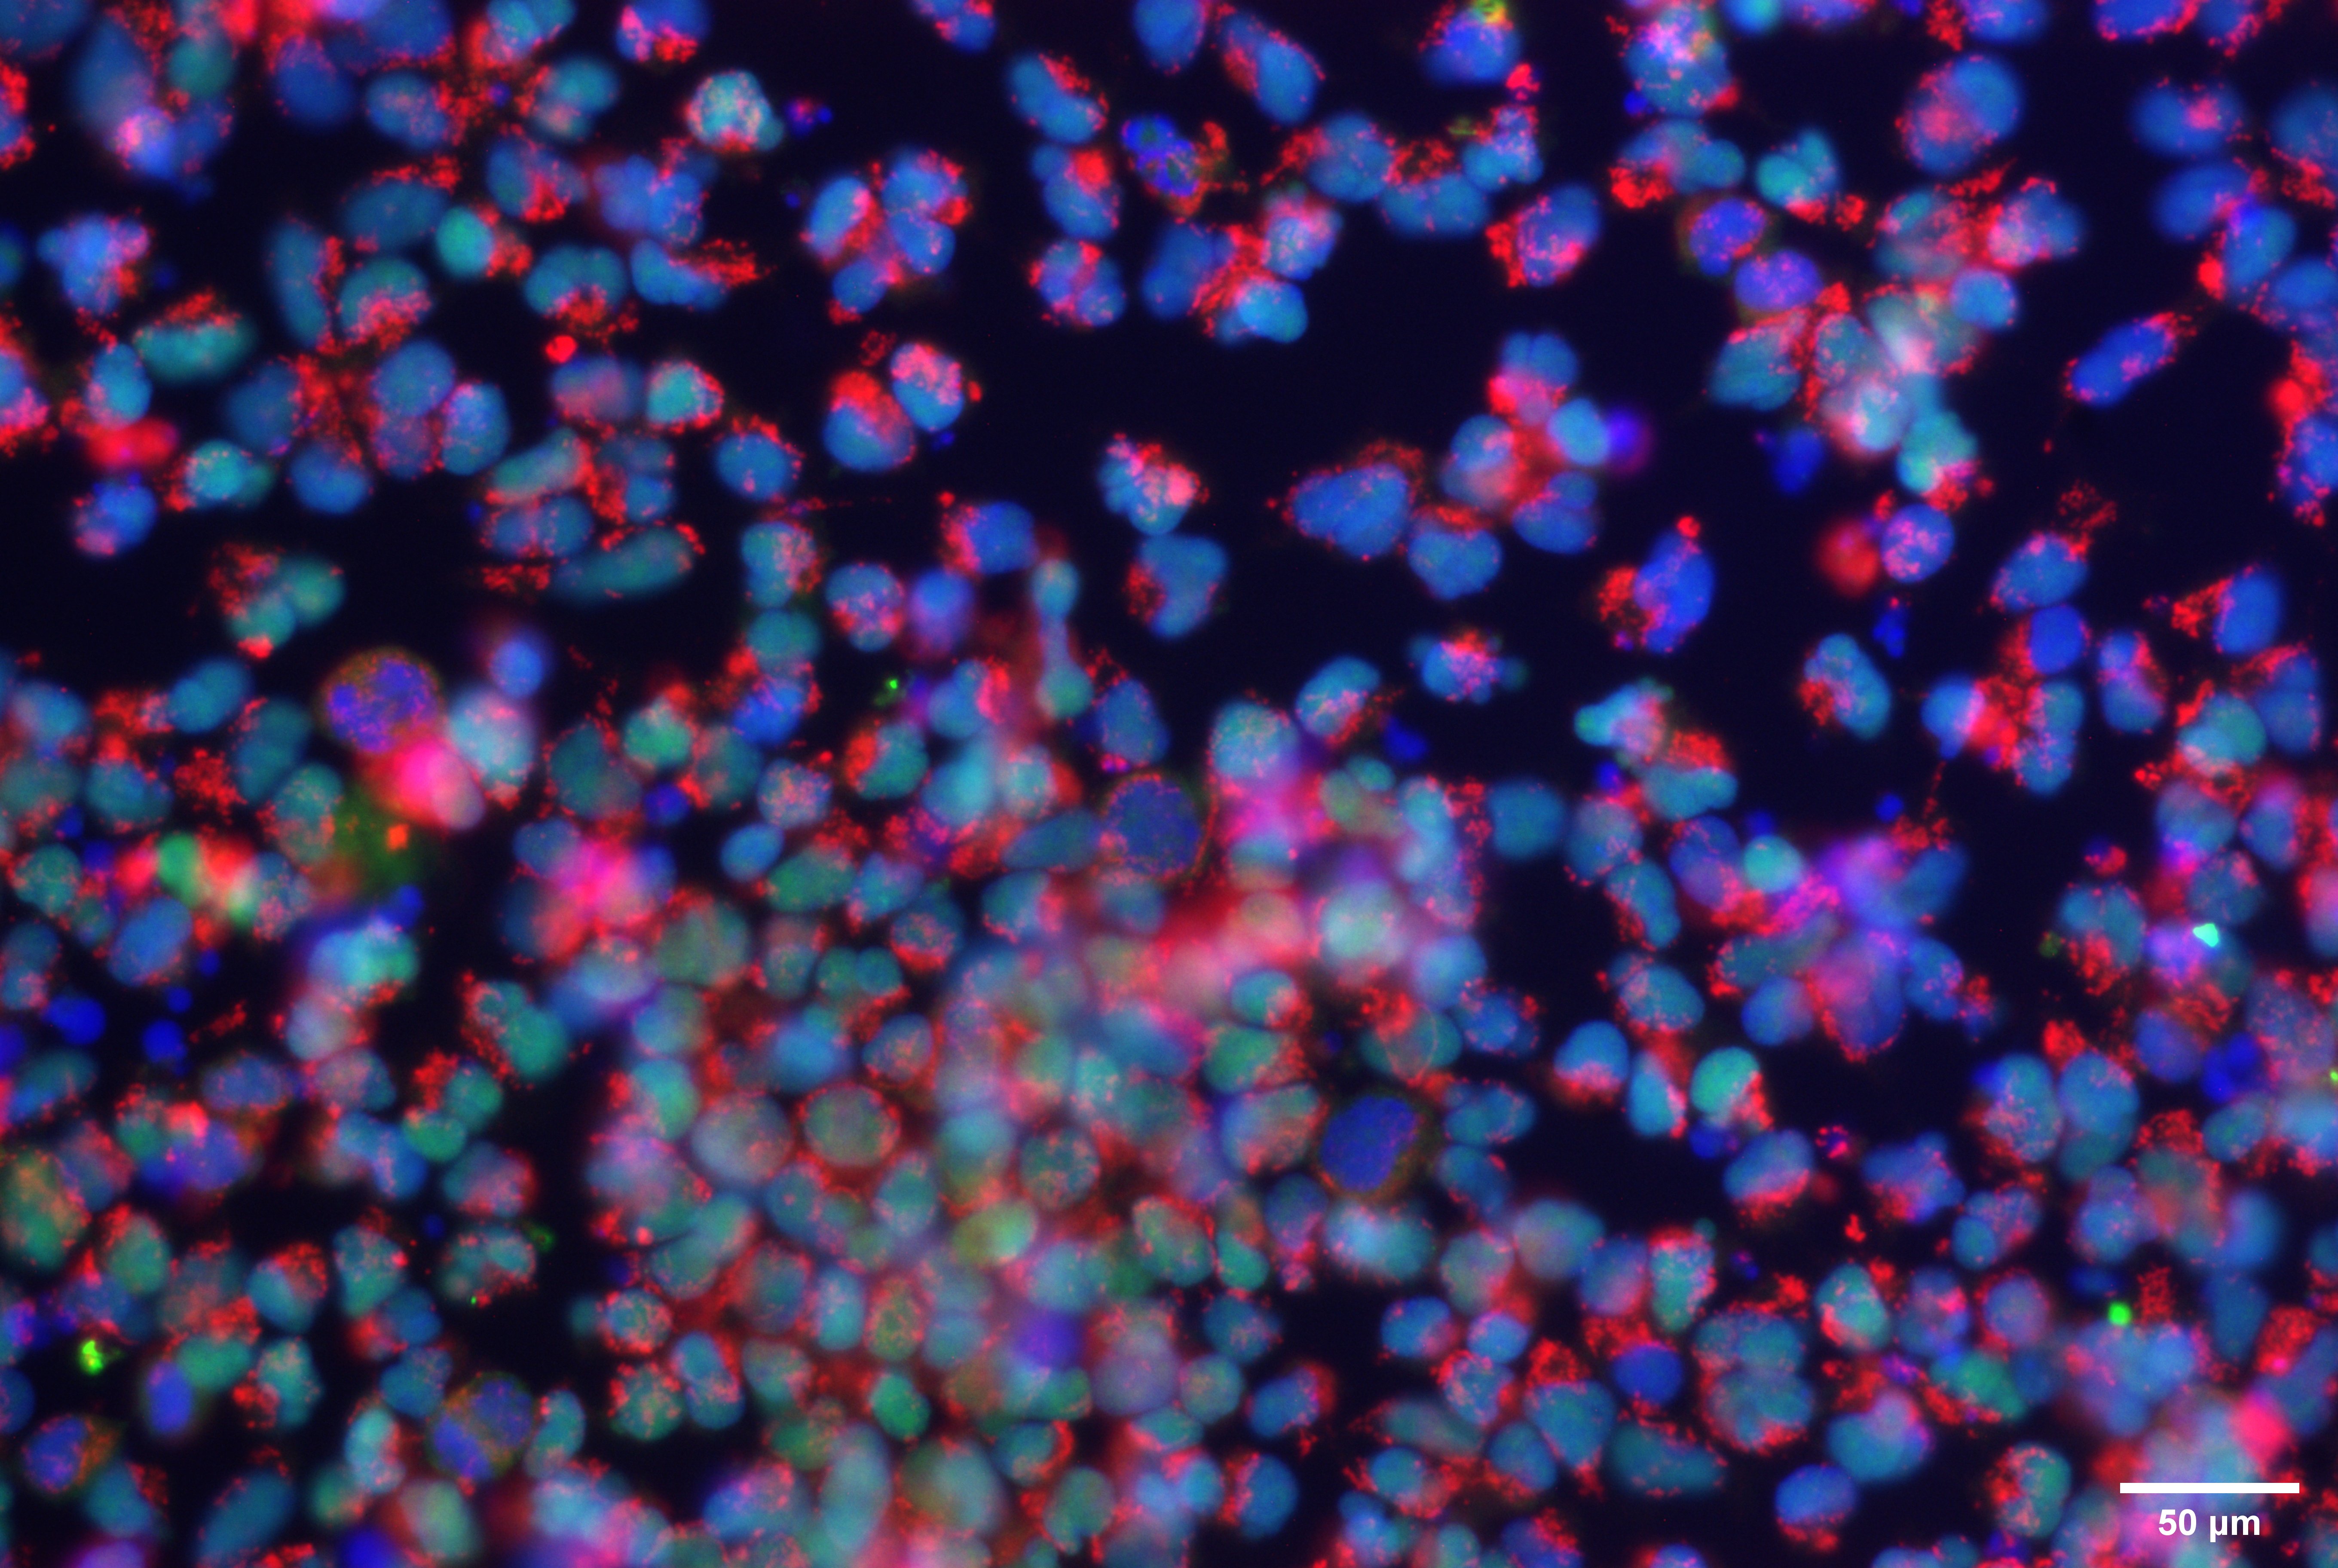

The cell line is not validated yet.
ZJUCi001-A
General
Cell Line |
|
| hPSCreg name | ZJUCi001-A |
| Cite as: | ZJUCi001-A |
| Cell line type | Human induced pluripotent stem cell (hiPSC) |
| Similar lines | No similar lines found. |
| Last update | 9th December 2025 |
| User feedback | |
Provider |
|
| Generator |
Zhejiang children hospital (ZJUC)
Contact:
Zhejiang children hospital (ZJUC) |
| Owner | Zhejiang children hospital (ZJUC) |
External Databases |
|
| BioSamples | SAMEA120784102 |
General Information |
|
| * Is the cell line readily obtainable for third parties? |
Yes Research use: allowed
Clinical use: not allowed
Commercial use: not allowed
|
Donor Information
General Donor Information |
|
| Sex | female |
Phenotype and Disease related information (Donor) |
|
| Diseases | A disease was diagnosed.
|
Karyotyping (Donor) |
|
| Has the donor karyotype been analysed? |
Yes
46,XX
Karyotyping method:
G-Banding
|
Other Genotyping (Donor) |
|
| Is there genome-wide genotyping or functional data available? |
No
|
External Databases (Donor) |
|
| BioSamples | SAMEA120784103 |
Ethics
| Has informed consent been obtained from the donor of the embryo/tissue from which the pluripotent stem cells have been derived? | Yes |
| Was the consent voluntarily given? | Yes |
| Has the donor been informed that participation will not directly influence their personal treatment? | Yes |
| Can you provide us with a copy of the Donor Information Sheet provided to the donor? | No |
| Do you (Depositor/Provider) hold the original Donor Consent Form? | Yes |
| Please indicate whether the data associated with the donated material has been pseudonymised or anonymised. | anonymised |
| Does consent explicitly allow the derivation of pluripotent stem cells? | No |
| * Does consent expressly prevent the derivation of pluripotent stem cells? | No |
| * Does consent pertain to a specific research project? | No |
| Does consent prevent CELLS DERIVED FROM THE DONATED BIOSAMPLE from being made available to researchers anywhere in the world? | No |
| How may genetic information associated with the cell line be accessed? | Open Access |
| Will the donor expect to receive financial benefit, beyond reasonable expenses, in return for donating the biosample? | No |
| Has a favourable opinion been obtained from a research ethics committee, or other ethics review panel, in relation to the Research Protocol including the consent provisions? | Yes |
| Name of accrediting authority involved? | Institutional Review Board/Ethical Committee of Children's Hospital, School of Medicine, Zhejiang University |
| Approval number | 2022-IRB-0306-P-01 |
| For generation of the cell line, who was the supplier of any recombined DNA vectors or commercial kits used? |
hIPSC Derivation
General |
|
| Source cell type |
A peripheral blood cell with a single nucleus. This category includes lymphocytes and monocytes.
Synonyms
|
Reprogramming method |
|
| Vector type | Non-integrating |
| Vector | Episomal |
| Genes | |
| Is reprogramming vector detectable? |
Yes |
| Methods used |
PCR
|
Vector free reprogramming |
|
Other |
|
| Derived under xeno-free conditions |
Unknown |
| Derived under GMP? |
Unknown |
| Available as clinical grade? |
Unknown |
Culture Conditions
| Medium |
mTeSR™ 1
|
| Has Rock inhibitor (Y27632) been used at passage previously with this cell line? | Yes |
| Has Rock inhibitor (Y27632) been used at cryo previously with this cell line? | No |
| Has Rock inhibitor (Y27632) been used at thaw previously with this cell line? | Yes |
Characterisation
Analysis of Undifferentiated Cells
| Marker | Expressed | Immunostaining | RT-PCR | Flow Cytometry | Enzymatic Assay | Expression Profiles |
| SSEA-4 |
Yes |
|||||
| SOX2 |
Yes |
| Marker | Present | Absent |
| mCpG | ||
| OCT4 |
Differentiation Potency
In vitro directed differentiation
| Marker | Expressed |
| SOX17 |
Yes |
| CXCR4 |
Yes |
In vitro directed differentiation
| Marker | Expressed |
| CXCR4 |
Yes |
| Brachyury |
Yes |
In vitro directed differentiation
| Marker | Expressed |
| PAX6 |
Yes |
| Nestin |
Yes |
Microbiology / Virus Screening |
|
| Mycoplasma | Negative |
Genotyping
Karyotyping (Cell Line) |
|
| Has the cell line karyotype been analysed? |
Yes
|
Other Genotyping (Cell Line) |
|

Login to share your feedback, experiences or results with the research community.